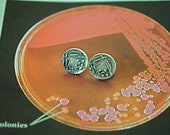

Welcome!
Hello! Thanks for stopping by!
NB Designs it is a one woman show based in lovely Pasadena California. From the design, fabrication, oxidizing, finishing, photography, copy writing and shipping I do it all by hand. I consider my pieces to be more art/fine silver sculpture than jewelry. My work reflects my interests, so there is a lot of science, writing and some other random interests/obsessions thrown in the mix too. I am a self taught artist and am still learning.
It is also important to note that all of my designs are made from PMC which is made using reclaimed silver. The jewelry business is a dirty one, so I keep my shop as green as possible. I use only products that contain reclaimed silver/ bronze/ copper and will only use lab grown/ cubic zirconia in my designs if I cannot find fair trade gems. I do this to make sure my eco foot print it kept as small as possible and to do my small part to protect the environment we all share.